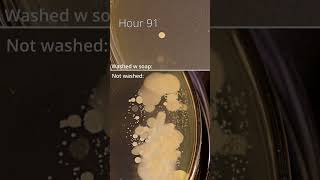

Welcome to Aman [RIMS]......
Hey there! I’m Aman, an Anesthesia Technologist passionate about sharing knowledge and insights from the world of medical science and healthcare.
On this channel, you’ll find:
🩺 Educational videos on medical concepts
💉 Practical insights into anesthesia technology
📚 Tips and explanations for medical students
🏥 Real-life hospital experiences and case discussions
Whether you’re a medical student, a healthcare professional, or just curious about how things work behind the scenes in medicine — this channel is for you!
👉 Subscribe and join me on the journey of learning and growing in the medical field.
Let’s make medicine simple and meaningful!
#MedicalStudies #AnesthesiaTechnology #AmanRIMS
.... thankyou...... Like...... share..
subscribe ..
Shared 56 years ago
8 views
Shared 56 years ago
49 views
Shared 56 years ago
20 views
Shared 56 years ago
7 views
Shared 56 years ago
122 views
Shared 56 years ago
274 views